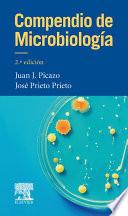

Enseñanza de las ciencias en tiempos de COVID-19
Autor: Abril Gallego, Ana María , Blanco López, Ángel , Franco Mariscal, Antonio Joaquín , Álvaro Mora, Nuria , Ametller I Leal, Jaume , Aragón Méndez, María Del Mar , Aragón Núñez, Lourdes , Borrull Riera, Anna , Bravo Lucas, Elena , Cabello Garrido, Aurelio , Cantó Doménech, José , Cañada Cañada, Florentina , Cara Torres, J. Beatriz , Carrasquer Álvarez, Beatriz , Cebrián Robles, Daniel , Cortés Gracia, Ángel Luis , Criado García-legaz, Ana María , Cruz Lorite, Isabel María , Cubero Juánez, Javier , De Pro Bueno, Antonio , De Pro Chereguini, Carlos , España Naveira, Paloma , España Ramos, Enrique , Ezquerra Martínez, Ángel , García Barros, Susanna , García Ruiz, Andrés , García Ruiz, Cristina , Garzón Fernández, Anabella , Gavidia Catalán, Valentín , Girón Gambero, Jesús Ramón , Gómiz Aragón, Marta , González García, Francisco , González García, Francisco José , Grimalt Álvaro, Carme , Guisasola Aranzabal, Jenaro , Hernández Del Barco, Miriam , Illescas Navarro, Mireia , Jiménez Liso, María Rut , López Banet, Luisa , Lupión Cobos, Teresa , Marcos Merino, José María , Márquez Bargalló, Conxita , Martínez Aznar, María Mercedes , Martínez Losada, Cristina , Mayoral García-berlanga, Olga , Mazas Gil, Beatriz , Montalbán Quesada, Alba , Muñoz Franco, Granada , Nebot Castelló, Maria Roser , Oliva Martínez, José María , Perales Palacios, Francisco Javier , Pérez Martín, José Manuel , Poz Miranda, Adrián , Quesada Armenteros, Antonio , Reig Armiñana, José , Rodríguez Losada, Noela , Rodríguez Ortega, Pilar Gema , Romero Ariza, Marta , Sáez Bondía, María José , Solbes Matarredona, Jordi , Solis Espallargas, María Del Carmen , Vallés Rapp, Cristina , Valls Bautista, Cristina
La situación de pandemia vivida en todo el mundo desde comienzos de 2020, ocasionada por el virus SARS-CoV-2, ha ofrecido una situación proclive a desarrollar alfabetización científica en la población, en general, y en la educación formal, en particular. Palabras como coronavirus, inmunidad de rebaño, mutación, cepas virales, ARN, antígenos, anticuerpos o PCR son términos habituales en los medios de comunicación y en las conversaciones cotidianas, por lo que, desde la educación formal, tenemos la obligación de, además de formar en conocimiento científico, desarrollar en los jóvenes la capacidad de análisis crítico de la información que les llega. Entendemos, ahora más que nunca, que la enseñanza de las ciencias debe ser contextualizada, basada en la realidad, que aborde controversias sociocientíficas, que plantee problemas desde el punto de vista del individuo, de la comunidad o globales y que acerque no solo el conocimiento científico sino también la forma en cómo este se construye. Este libro ofrece a los docentes de las diferentes etapas educativas información básica para afrontar la enseñanza de los contenidos científicos relacionados con la...